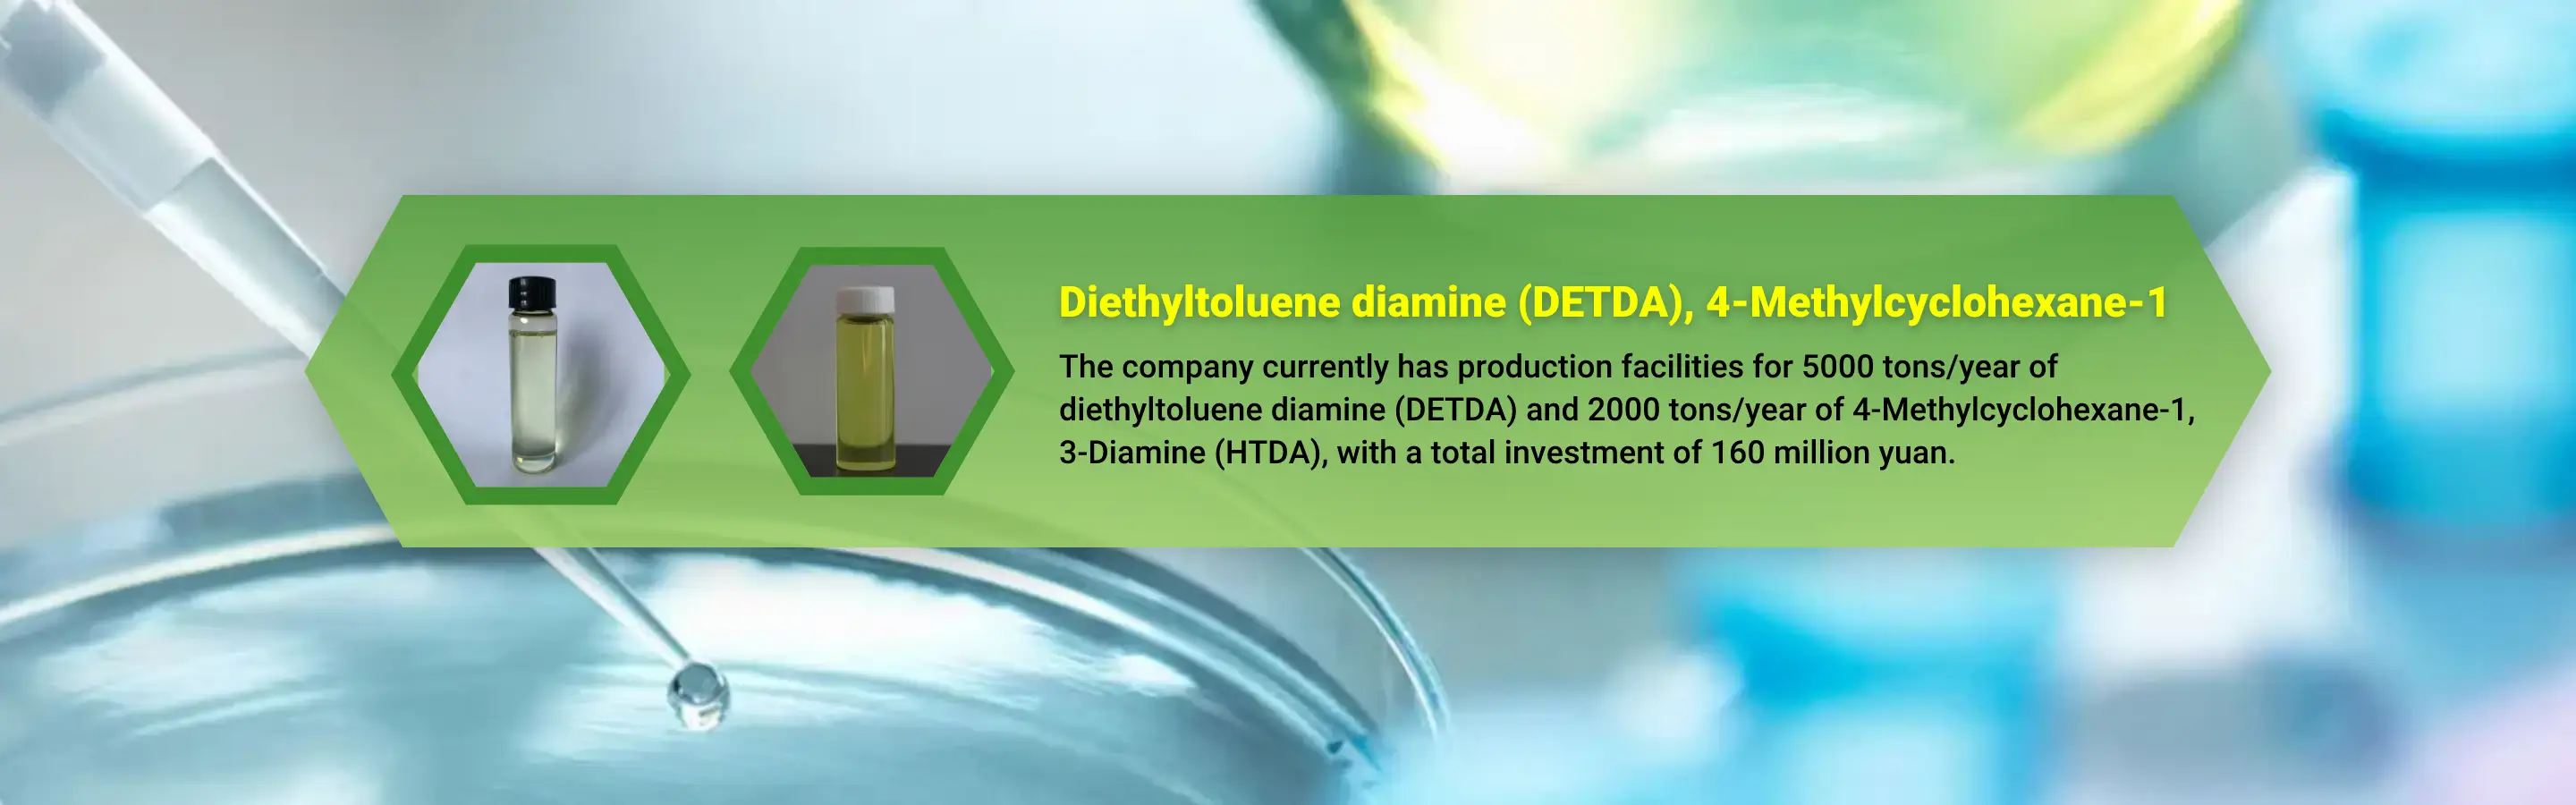

On Chemball
My Chemball
+86-571-8627 3270

Henan Leibairui New Material Technology Co.,Ltd.
Henan Leibairui New Material Technology Co.,Ltd.
Main Products:
Diethyltoluenediamine / 4-Methylcyclohexane-1,3-Diamine
VERIFIEDMANUFACTURINGCOMPANY
Business Type
Manufacturing
Total Employees
100-500
People
Plant Size
22
Acres
Production Experience
9+
Years
Registered Capital
CNY 15 Million
MAIN
PRODUCTS
More
PRODUCTS
1/6
Diethyltoluenediamine / DETDA / E100 / Diethyl Methyl Benzene Diamine
CAS: 68479-98-1
Specification:
Purity≥98%
Packing:
200 KG/Iron Drum; 1000 KG/IBC Drum
Lead Time:
1-2 weeks
1/6
4-Methylcyclohexane-1,3-Diamine / HTDA / 2,4-Diamino-1-Methylcyclohexane
CAS: 13897-55-7
Specification:
Purity≥99.5%
Packing:
900 KG/IBC Drum; 0 KG/Customed Package
Lead Time:
In Stock
ABOUT US
Henan Leibairui New Material Technology Co.,Ltd.
Henan Leibairui New Material Technology Co., Ltd. currently has 130 employees, including 10 with senior professional titles, 15 with intermediate professional titles, and 12 with technical research and development.
The company currently has production facilities for 5000 tons/year of diethyltoluene diamine (DETDA) and 2000 tons/year of 4-Methylcyclohexane-1,3-Diamine (HTDA), with a total investment of 160 million yuan. Completed and put into operation in November 2017 and August 2020 respectively; It is expected that a 20000 ton/year 4-Methylcyclohexane-1,3-Diamine (HTDA) production unit will be put into operation in the second half of 2023.
The company currently has products such as diethyltoluene diamine (DETDA), 4-Methylcyclohexane-1,3-Diamine (HTDA), NH-100, CL-1000, etc. Our company has established long-term and stable cooperative relationships with multiple universities and research institutes, with the business philosophy of technology leading, innovative development, customer first, and win-win cooperation. We are market-oriented and focus on the research and development, production, and sales of polyurethane, epoxy resin, coating curing agents, and chain extenders. We can also conduct targeted research and development and production according to customer needs, wholeheartedly providing customers with the products and services they need.
View More

MANUFACTURING CAPABILITY & EHS
Testing Device
GC
IR
MS
EHS
Self-treatment
Emergency measure
COMPANY INTRODUCTION
Nearest Port
Lianyungang Port
Nearest Airport
Zhengzhou Xinzheng International Airport
Nearest Key City
Beijing
Distance to Key City
480KM
















CERTIFICATES
| Quality | ISO9001(English) ISO9001(English) ISO9001(Chinese) |
| EHS | ISO45001 ISO14001 |
TELL US WHAT YOU NEED
Submit Requirement
CONTACT US
Henan Leibairui New Material Technology Co.,Ltd.
Manager Ge(Export Manager)
-
North of the road, 1 kilometer west of the intersection of Jianshe and Pushui Road in Hualong District, Puyang City, Henan Province, China
Send Email